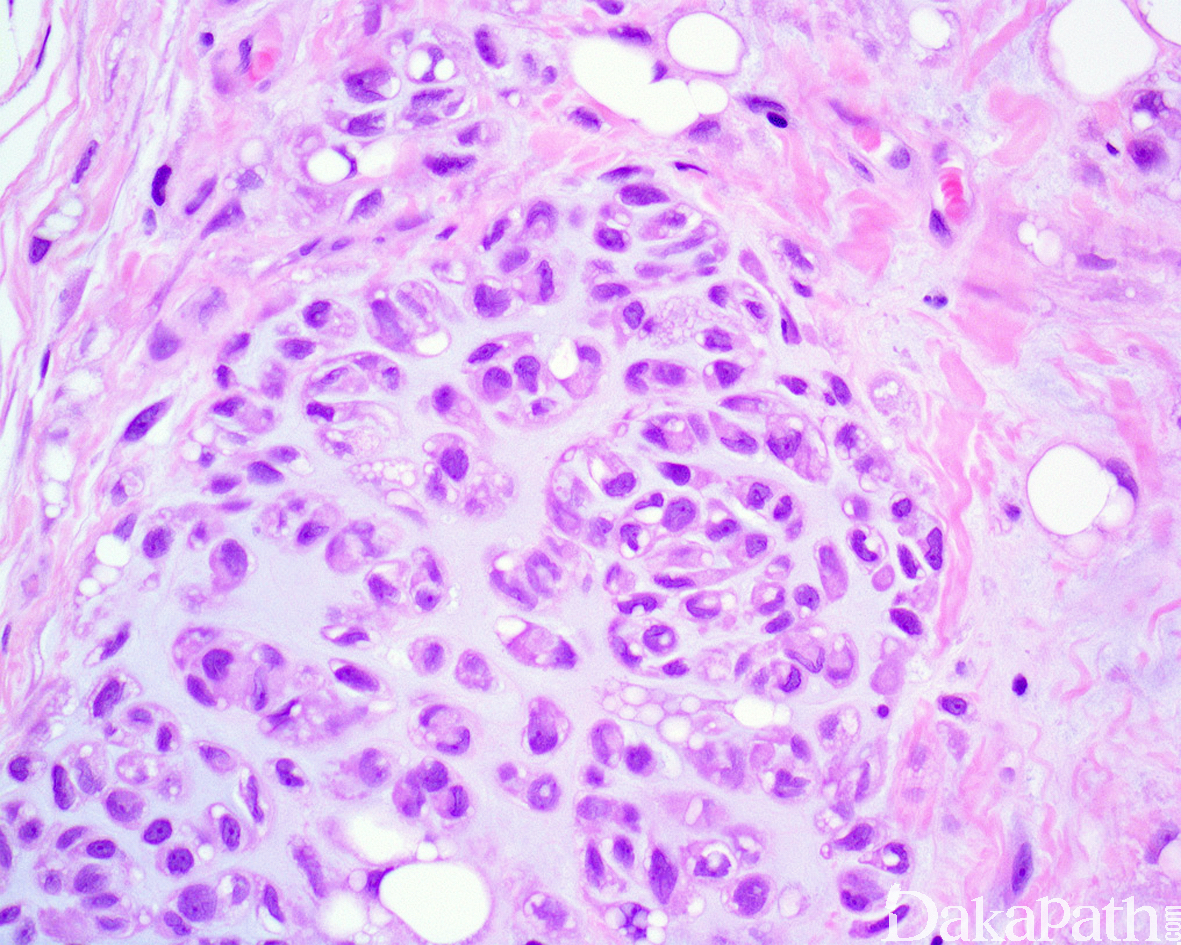

软骨样脂肪瘤
Chondroid Lipoma
概述:
是一种脂肪瘤的特殊亚型,肿瘤由脂肪母细胞和成熟脂肪组织构成,基质呈软骨黏液样或黏液玻璃样变样。
发病部位: 四肢近端和肢带、罕见于躯干、头颈部、手足等。
诊断要点:
好发于中青年(中位年龄 28-36 岁),女性多见(女/男约 4:1),以肢体近端最多见;
肿瘤 1.5-11cm(中位大小约 4.0cm),可位于皮下至肌内等多个平面,大体上边界清楚,可见包膜,切面分叶状;
镜下肿瘤边界清楚,由薄的纤维性间质分隔呈小叶状;
小叶由位于软骨黏液样基质内的片状、巢状或索状圆细胞以及数量不等的成熟脂肪细胞组成;
圆细胞胞浆空泡状或嗜酸性颗粒状,有时可见多个空泡形成并挤压核形成核切迹从而类似于脂肪母细胞;
瘤细胞核卵圆形或肾形,核染色质均匀细腻,核仁不明显或含小的嗜碱性核仁,无核异型性,核分裂像罕见;
基质呈软骨黏液样或黏液玻璃样变样,围绕嗜酸性或空泡状细胞周围形成类似于软骨的陷窝;
肿瘤内血管丰富(各种口径大小的血管均可见,较小的血管常见血栓形成),常见灶性出血和纤维化,偶见钙化或骨化以及慢性炎细胞浸润。
免疫组织化学染色:
脂肪细胞 S-100 阳性,空泡状细胞不同程度的表达 S100 蛋白、vimentin 和 CD68,部分表达 IV 胶原和 cyclinD1,少数病例 CK 或 Cam5.2 灶性阳性;单或多泡状的脂肪母细胞样细胞油红 O 染色阳性;黏液样基质 AB 染色和胶体铁染色阳性。不表达 calponin,CD34,HMB45, SMA, MSA,CD57 和 GFAP 等。
分子标记:
t(11;16)(q13;p12-13)导致 C11orf95-MKL2 基因融合
鉴别诊断:
- 骨外黏液性软骨肉瘤 :肿瘤呈多结节状或分叶状,瘤细胞多呈纤细的条索状、花边样或网格状排列,形态较为一致,卵圆形、短梭形或星状,胞质内很少或不含有空泡,肿瘤内多不含成熟性的脂肪组织。
- 黏液性脂肪肉瘤 :肿瘤内可见分支状或丛状的毛细血管网,血管周围常可见到不同分化阶段的脂肪细胞细胞;90%的病例具有 t(1 2;1 6)(q1 3;p 11),产生 CHOPOP-FUS 融合性基因。
- 软组织肌上皮瘤:上皮性结构,通常无成熟的脂肪成分,免疫组化染色表达 AE1/3,EMA,SMA,S100 蛋白以及 SOX10 等;
- 软组织软骨瘤 :手指、脚趾、手、脚出现;包含真透明软骨 ;缺乏脂肪成分。
预后:
良性
治疗:
单纯手术切除治愈;无复发或转移
参考文献:
Flucke U et al: Presence of C11orf95-MKL2 fusion is a consistent finding in chondroid lipomas: a study of eight cases. Histopathology. 62(6):925-30, 2013
Thway K et al: Chondroid lipoma: an update and review. Ann Diagn Pathol. 16(3):230-4, 2012
De Vreeze RS et al: Delineation of chondroid lipoma: an immunohistochemical and molecular biological analysis. Sarcoma. 2011:638403, 2011
Ballaux F et al: Chondroid lipoma is characterized by t(11;16)(q13;p12-13). Virchows Arch. 444(2):208-10, 2004
Thomson TA et al: Cytogenetic and cytologic features of chondroid lipoma of soft tissue. Mod Pathol. 12(1):88-91, 1999
Kindblom LG et al: Chondroid lipoma: an ultrastructural and immunohistochemical analysis with further observations regarding its differentiation. Hum Pathol. 26(7):706-15, 1995
Nielsen GP et al: Chondroid lipoma, a tumor of white fat cells. A brief report of two cases with ultrastructural analysis. Am J Surg Pathol. 19(11):1272-6, 1995